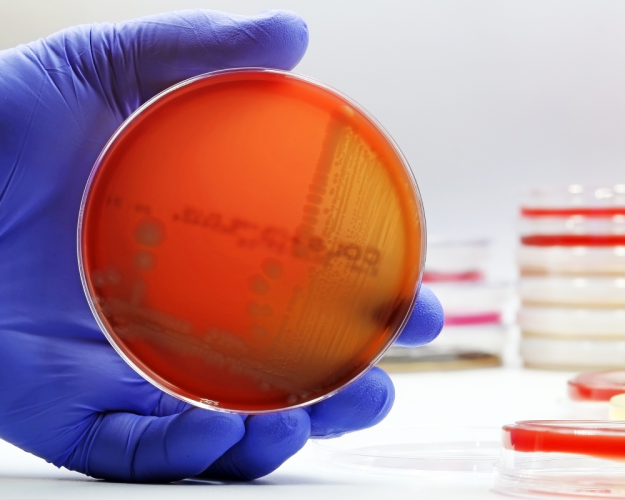
Current recall: STEC/VTEC in beef sausages Current recall: STEC/VTEC in beef sausages

Current recall: STEC/VTEC in beef sausages
Oct 27, 2025 - Foods
Current recall: STEC/VTEC in beef sausages
Currently, lebensmittelwarnung.de is recalling beef crackers due to the detection of Shiga toxin-producing/Verotoxin-producing Escherichia coli (STEC/VTEC) during analyses.
Some strains of E. coli, such as STEC (Shiga toxin-producing Escherichia coli) and VTEC (Verotoxin-producing E. coli), can cause serious foodborne illnesses. Infections often manifest with classic symptoms such as gastrointestinal discomfort (vomiting, diarrhea, fever, etc.). However, in particularly severe cases, pathogenic Escherichia coli strains can also trigger kidney failure and life-threatening conditions.
The presence of these pathogenic Escherichia coli strains in ready-to-eat foods is therefore undesirable, and measures must be taken when live STEC/VTEC are detected in ready-to-eat foods.
At BAV Institute, we regularly conduct examinations for STEC/VTEC in both animal and plant-based foods. We provide you with fast and reliable results and are happy to advise you on all matters related to product safety. If you have any questions, our customer advisors are available to assist you.
Source:
- Food warning: www.lebensmittelwarnung.de
- BAV Institute: www.bav-institut.de
- BfR: www.bfr.bund.de
